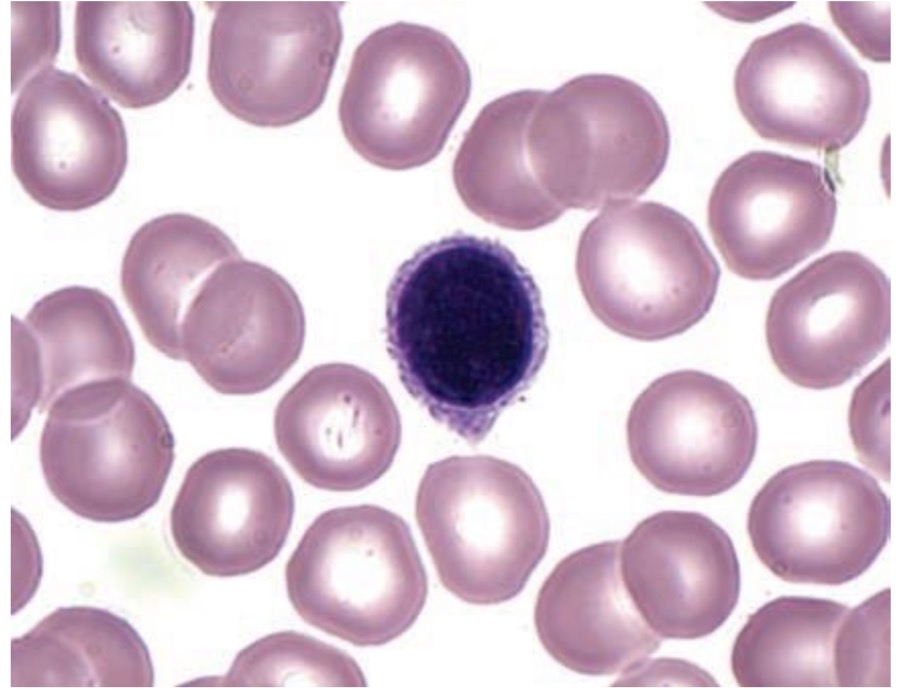
<p>Answer the questions in these following pictures</p>

Histology OSPE 2025-2026
1/54
There's no tags or description
Looks like no tags are added yet.
Name | Mastery | Learn | Test | Matching | Spaced |
|---|
No study sessions yet.
55 Terms

Identify the tissue and mention one site
Simple squamous epithelium
Aorta

Identify the tissue and mention one site
Simple squamous epithelium
Aorta

Identify the tissue and mention one site
Simple squamous epithelium
Aorta

Identify the tissue and mention one site
Keratinized stratified squamous epithelium
Epidermis of the skin

Identify the tissue and mention one site
Keratinized stratified squamous epithelium
Epidermis of skin

Identify the tissue and mention one site
Neuroepithelium
Taste buds

Identify the tissue and mention one site
Neuroepithelium
Taste buds

Identify the tissue and mention one site
Neuroepithelium
Taste buds

Identify the tissue and mention one site
Non-keratinized stratified squamous epithelium
Esophagus

Identify the tissue and mention one site
Non-Keratinized stratified squamous epithelium
Esophagus

Identify the tissue and mention one site
Non-keratinized stratified squamous epithelium
Oesophagus

Identify the tissue and mention one site
Non-keratinized stratified squamous epithelium
Oesophagus

Identify this tissue and mention one site
Non-keratinized stratified squamous epithelium
Oesophagus

Identify the tissue and mention one site
Simple cuboidal epithelium
Thyroid follicles

Identify the tissue and mention one site
Simple cuboidal epithelium
Thyroid follicles

Identify the tissue and mention one site
Simple cuboidal epithelium
Thyroid follicles

Identify the tissue and mention one site
Simple cuboidal epithelium
Thyroid follicles

Identify the tissue and mention one site
Transitional epithelium
Urinary bladder

Identify the tissue and mention one site
Transitional epithelium
Urinary bladder

Identify the tissue and mention one site
Transitional epithelium
Urinary bladder

Identify the tissue and mention one site
Transitional epithelium
Urinary Bladder

Identify the tissue and mention one site
Transitional epithelium
Urinary Bladder

Identify the tissue and mention some sites
Dense regular collagenous CT
(Main) in tendons

Identify the tissue and mention one site
Dense regular collagenous CT
Tendons Other

Identify the tissue and mention one site
Dense regular collagenous CT
Tendons Other

Identify the tissue and mention one site
Dense regular collagenous CT
Tendons Other

Identify the tissue and mention one site
Unilocular adipose CT
Adult subcutaneous tissue

Identify the tissue and mention one site
Unilocular Adipose CT
Adult subcutaneous tissue

Identify the tissue and mention one site
Mucoid CT
Umbilical cord

Identify the tissue and mention one site
Mucoid CT
Umbilical cord

Identify the tissue and mention one site and mention the stain used
Dense regular elastic CT
Aorta
Ver Hoef’s stain

Identify the tissue and mention one site
Dense regular elastic CT
Aorta

Identify the tissue and mention one site
Dense regular collagenous CT
Tendons
Other sites are ligaments and Corneal stroma

Answer the questions in these following pictures
1-Lipid
2-Transmembrane protein
3-Sugar chain of glycolipid

Answer the questions in these following pictures
1- (7.5-10)
2- Trilaminar appearance

Answer the questions in these following pictures
1-Mitochondia
2-Cristae
3-Power house of the cell

Answer the questions in these following pictures
1-Free ribosomes /Polysomes
2-Basophilic
3-Synthesize protein for the use of the cell

Answer the questions in these following pictures
1-RER
2-Basophilic
3-segregation of protein
And initial glycosylation of protein

Answer the questions in these following pictures
1-Glycogen metabolism in liver cells and Lipid biosynthesis and etc…
2-Muscles testis adrenal gland ovary and Liver

Answer the questions in these following pictures
1- Golgi apparatus
2-
A- Transfer vesicles
B- Golgi saccules
C- Secretory vesicles

Answer the questions in these following pictures
1-Golgi apparatus
2-Synthesis of GAGs in CT ECM,
Final glycosylation of proteins.
Concentrate package and store protein
Form primary lysosomes

Answer the questions in these following pictures
1-Secondary Lysosomes
2-
A- Heterolysosomes
B-Multivesicular Body

Answer the questions in these following pictures
A- Actin filaments
B- Myosin filaments

Answer the questions in these following pictures
1-Centrioles
2-Formation of Cilia/Flagella

Answer the questions in these following pictures
1-Shaft of cilia
2- 20 microtubules (9 doublets and 2 central singlets)

Answer the questions in these following pictures
1-shaft of cilia
2-EM (Surface scanning/ SEM)

Answer the questions in these following pictures
1-Glycogen granules
2-Best’s carmine
3-LIver

Answer the questions in these following pictures
1-Alpha glycogen granules under EM
2- alpha types

Answer the questions in these following pictures
1-Beta glycogen granules
2-Beta types
3-Muscles

Answer the questions in these following pictures
1-Lipid inclusion/ droplets
2-Osmic acid

Answer the questions in these following pictures
1-Rounded
2-MultiLobed
3-kidney shaped
Arrow- Nucleolus

Answer the questions in these following pictures
Vesicular/ open-face nucleus
Answer the questions in these following pictures
Condensed nucleus

Answer the questions in these following pictures
N: Nucleolus
1-Peripheral Chromatin
2-Nucleolar-associated chromatin
3-Chromatin islands
4-Nuclear sap

Answer the questions in these following pictures
1- Vesicular Nucleus
Arrow- Nuclear membrane
3- 1) Nucleolus
2)Peripheral protein
3) Nuclear sap